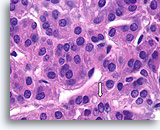
Image 3

Afbeelding 13
Benigne, hyperplastisch/adenomatoïde nodule, schildklier FNA, celblok.
Het celblok dat overeenkomt met afbeelding 11-12 toont een duidelijk bijvoeging van micro- en macrofollikels. Er zijn twee kenmerken die voor een benigne nodule pleiten. Het eerste is dat de microfollikels afgeplat cytoplasma vertonen, vergeleken met de robuuster uitziende macrofolliculaire cellen (vergelijk de hoogte van het cytoplasma bij de twee pijlen). Een tweede kenmerk is de variatie in het uiterlijk van het colloïd tussen de verschillende follikels. Let op het oedemateuze colloïd in het ene follikel dat zich naast een follikel bevindt met dicht opeengepakt colloïd (open pijlen). Van benigne hyperplastisch/adenomatoïde nodulen wordt verwacht dat ze heterogeniteit vertonen, terwijl folliculaire neoplasmen monotoner zijn.
40X
Afbeelding 13
Benigne, hyperplastisch/adenomatoïde nodule, schildklier FNA, celblok.
Het celblok dat overeenkomt met afbeelding 11-12 toont een duidelijk bijvoeging van micro- en macrofollikels. Er zijn twee kenmerken die voor een benigne nodule pleiten. Het eerste is dat de microfollikels afgeplat cytoplasma vertonen, vergeleken met de robuuster uitziende macrofolliculaire cellen (vergelijk de hoogte van het cytoplasma bij de twee pijlen). Een tweede kenmerk is de variatie in het uiterlijk van het colloïd tussen de verschillende follikels. Let op het oedemateuze colloïd in het ene follikel dat zich naast een follikel bevindt met dicht opeengepakt colloïd (open pijlen). Van benigne hyperplastisch/adenomatoïde nodulen wordt verwacht dat ze heterogeniteit vertonen, terwijl folliculaire neoplasmen monotoner zijn.
40X

Afbeelding 14
Benigne, hyperplastisch/adenomatoïde nodule, schildklier FNA, celblok.
Let op het afgeplatte cytoplasma in e microfollikels vergeleken met het kubusvormige tot cilindrische cytoplasma van het macrofolliculaire epitheel linksboven. Let ook op het waterige colloïde in één follikel (pijl) vergeleken met het dicht opeengepakte colloïde in de microfollikels.
40X
Afbeelding 14
Benigne, hyperplastisch/adenomatoïde nodule, schildklier FNA, celblok.
Let op het afgeplatte cytoplasma in e microfollikels vergeleken met het kubusvormige tot cilindrische cytoplasma van het macrofolliculaire epitheel linksboven. Let ook op het waterige colloïde in één follikel (pijl) vergeleken met het dicht opeengepakte colloïde in de microfollikels.
40X

Afbeelding 15
Benigne, hyperplastisch/adenomatoïde nodule, schildklier FNA, celblok.
Dicht fibreus weefsel (niet actief desmoplastisch) met hemosiderine en beduidend atrofische, afgeplatte follikels kunnen worden waargenomen.
40X
Afbeelding 15
Benigne, hyperplastisch/adenomatoïde nodule, schildklier FNA, celblok.
Dicht fibreus weefsel (niet actief desmoplastisch) met hemosiderine en beduidend atrofische, afgeplatte follikels kunnen worden waargenomen.
40X

Afbeelding 16
Benigne, hyperplastisch/adenomatoïde nodule, schildklier FNA, celblok.
Dun colloïde linksonder vergeleken met het dichtere colloïde in de microfollikels pleit samen met het afgeplatte, atrofische uiterlijk van de folliculaire cellen in de microfollikels voor een benigne hyperplastische/adenomatoïde nodule.
40X
Afbeelding 16
Benigne, hyperplastisch/adenomatoïde nodule, schildklier FNA, celblok.
Dun colloïde linksonder vergeleken met het dichtere colloïde in de microfollikels pleit samen met het afgeplatte, atrofische uiterlijk van de folliculaire cellen in de microfollikels voor een benigne hyperplastische/adenomatoïde nodule.
40X

Afbeelding 17
Benigne, hyperplastisch/adenomatoïde nodule, schildklier FNA, celblok.
De weefselarchitectuur die hier aanwezig is, illustreert de variabiliteit in het cytoplasma tussen aangrenzende follikels, waarbij de met pijlen gemarkeerde follikels een wisselende mate van hürthlecelverandering vertonen, vergeleken met de niet gemarkeerde follikels.
40X
Afbeelding 17
Benigne, hyperplastisch/adenomatoïde nodule, schildklier FNA, celblok.
De weefselarchitectuur die hier aanwezig is, illustreert de variabiliteit in het cytoplasma tussen aangrenzende follikels, waarbij de met pijlen gemarkeerde follikels een wisselende mate van hürthlecelverandering vertonen, vergeleken met de niet gemarkeerde follikels.
40X

Afbeelding 18
Folliculair neoplasma, schildklier FNA, celblok.
De uniformiteit van het cytoplasma, de robuuste cilindrische epitheelcellen, de microfolliculaire ordening, de afwezigheid van hemosiderine en de eenvormigheid van het colloïde pleiten in dit ene veld voor een folliculair neoplasma.
40X
Afbeelding 18
Folliculair neoplasma, schildklier FNA, celblok.
De uniformiteit van het cytoplasma, de robuuste cilindrische epitheelcellen, de microfolliculaire ordening, de afwezigheid van hemosiderine en de eenvormigheid van het colloïde pleiten in dit ene veld voor een folliculair neoplasma.
40X

Afbeelding 19
Cellaesie, folliculair neoplasma (lymfocytische thyroïditis vs hurthlecelneoplasma) kan niet worden uitgesloten, schildklier FNA, ThinPrep®.
De hurthlecellen hebben een microfolliculaire organisatie. Er zijn een paar lymfocyten door het epitheel gemengd, hetgeen pleit voor lymfocytische thyroïditis.
60X
Afbeelding 19
Cellaesie, folliculair neoplasma (lymfocytische thyroïditis vs hurthlecelneoplasma) kan niet worden uitgesloten, schildklier FNA, ThinPrep®.
De hurthlecellen hebben een microfolliculaire organisatie. Er zijn een paar lymfocyten door het epitheel gemengd, hetgeen pleit voor lymfocytische thyroïditis.
60X

Afbeelding 20
Benigne, lymfocytische thyroïditis, schildklier FNA, celblok.
Deze afbeelding van de patiënt in afbeelding 19 toont een dicht lymfocytisch infiltraat met aangrenzende afgeplatte microfollikels met hurthlecelveranderingen.
20X
Afbeelding 20
Benigne, lymfocytische thyroïditis, schildklier FNA, celblok.
Deze afbeelding van de patiënt in afbeelding 19 toont een dicht lymfocytisch infiltraat met aangrenzende afgeplatte microfollikels met hurthlecelveranderingen.
20X

Afbeelding 21
Benigne, lymfocytische thyroïditis, schildklier FNA, celblok.
Bij een sterkere vergroting kan de infiltratie van de follikels met lymfocyten worden waargenomen.
40X
Afbeelding 21
Benigne, lymfocytische thyroïditis, schildklier FNA, celblok.
Bij een sterkere vergroting kan de infiltratie van de follikels met lymfocyten worden waargenomen.
40X

Afbeelding 22
Benigne, lymfocytische thyroïditis, schildklier FNA, celblok.
Hier wordt een lymfoïde germinaal centrum afgebeeld.
40X
Afbeelding 22
Benigne, lymfocytische thyroïditis, schildklier FNA, celblok.
Hier wordt een lymfoïde germinaal centrum afgebeeld.
40X

Afbeelding 23
Cellulair laesie, folliculair neoplasma kan niet worden uitgesloten (hürthlecelneoplasma vs lymfocytische thyroïditis), schildklier, ThinPrep®.
Er is een microfolliculaire groep hürthlecellen met enkele mogelijke lymfocyten aanwezig.
60X
Afbeelding 23
Cellulair laesie, folliculair neoplasma kan niet worden uitgesloten (hürthlecelneoplasma vs lymfocytische thyroïditis), schildklier, ThinPrep®.
Er is een microfolliculaire groep hürthlecellen met enkele mogelijke lymfocyten aanwezig.
60X

Afbeelding 24
Folliculair neoplasma, hurthleceltype, schildklier FNA, celblok.
Deze afbeelding van de patiënt in afbeelding 23 toont de uniformiteit van de hürthlecelpopulatie die, samen met het robuuste cytoplasma in microfollikels, pleit voor een hürthlecelneoplasma.
40X
Afbeelding 24
Folliculair neoplasma, hurthleceltype, schildklier FNA, celblok.
Deze afbeelding van de patiënt in afbeelding 23 toont de uniformiteit van de hürthlecelpopulatie die, samen met het robuuste cytoplasma in microfollikels, pleit voor een hürthlecelneoplasma.
40X

Afbeelding 25
Folliculair neoplasma, hurthleceltype, schildklier FNA, celblok.
De omvang van de hürthlecelveranderingen is te groot om een reactie te kunnen zijn op zeldzame bijgevoegde lymfoïdecellen.
40X
Afbeelding 25
Folliculair neoplasma, hurthleceltype, schildklier FNA, celblok.
De omvang van de hürthlecelveranderingen is te groot om een reactie te kunnen zijn op zeldzame bijgevoegde lymfoïdecellen.
40X

Afbeelding 26
Folliculair neoplasma, hürthleceltype, schildklier FNA, ThinPrep®.
Op deze afbeelding ziet u een uniform microfolliculaire ordening van robuust uitziende hürthlecellen zonder lymfocyten.
60X
Afbeelding 26
Folliculair neoplasma, hürthleceltype, schildklier FNA, ThinPrep®.
Op deze afbeelding ziet u een uniform microfolliculaire ordening van robuust uitziende hürthlecellen zonder lymfocyten.
60X

Afbeelding 27
Folliculair neoplasma, hürthleceltype, schildklier FNA, ThinPrep®.
Deze opeengepakte groep bestaat uit relatief uniforme cellen met dicht, korrelig cytoplasma.
60X
Afbeelding 27
Folliculair neoplasma, hürthleceltype, schildklier FNA, ThinPrep®.
Deze opeengepakte groep bestaat uit relatief uniforme cellen met dicht, korrelig cytoplasma.
60X

Afbeelding 28
Folliculair neoplasma, hurthleceltype, schildklier FNA, celblok.
Deze afbeelding is van dezelfde patiënt als in afbeelding 26-27 en toont uniforme hürthlecelveranderingen, microfolliculaire ordening en afwezigheid van lymfocyten.
20X
Afbeelding 28
Folliculair neoplasma, hurthleceltype, schildklier FNA, celblok.
Deze afbeelding is van dezelfde patiënt als in afbeelding 26-27 en toont uniforme hürthlecelveranderingen, microfolliculaire ordening en afwezigheid van lymfocyten.
20X

Afbeelding 29
Folliculair neoplasma, hurthleceltype, schildklier FNA, celblok.
Een ander gebied toont grotere fragmenten met een monotone populatie over een bereik van verschillende honderden microns en pleit voor een diagnose van een neoplasma.
20X
Afbeelding 29
Folliculair neoplasma, hurthleceltype, schildklier FNA, celblok.
Een ander gebied toont grotere fragmenten met een monotone populatie over een bereik van verschillende honderden microns en pleit voor een diagnose van een neoplasma.
20X

Afbeelding 30
Folliculair neoplasma, hurthleceltype, schildklier FNA, celblok.
Een sterkere vergroting toont de ronde keren en duidelijke chromatinedeeltjes van de hürthlecellen.
100X
Afbeelding 30
Folliculair neoplasma, hurthleceltype, schildklier FNA, celblok.
Een sterkere vergroting toont de ronde keren en duidelijke chromatinedeeltjes van de hürthlecellen.
100X

Afbeelding 31
Folliculair neoplasma, schildklier FNA, ThinPrep®.
Op deze afbeelding met kleine vergroting ziet u drie groepen met uniforme microfollikels.
10X
Afbeelding 31
Folliculair neoplasma, schildklier FNA, ThinPrep®.
Op deze afbeelding met kleine vergroting ziet u drie groepen met uniforme microfollikels.
10X

Afbeelding 32
Folliculair neoplasma, schildklier FNA, celblok.
Deze afbeelding is van de patiënt in afbeelding 31. Macrofollikels kunnen worden waargenomen, maar er zijn geen cystische veranderingen en de overvloedig aanwezige tussenliggende microfollikels zijn uniform.
10X
Afbeelding 32
Folliculair neoplasma, schildklier FNA, celblok.
Deze afbeelding is van de patiënt in afbeelding 31. Macrofollikels kunnen worden waargenomen, maar er zijn geen cystische veranderingen en de overvloedig aanwezige tussenliggende microfollikels zijn uniform.
10X

Afbeelding 33
Folliculair neoplasma, schildklier FNA, celblok.
Een sterkere vergroting toont de robuuste cilindervormige follikels en de enigszins atypische, maar monotone celpopulatie die microfollikels vormen.
40X
Afbeelding 33
Folliculair neoplasma, schildklier FNA, celblok.
Een sterkere vergroting toont de robuuste cilindervormige follikels en de enigszins atypische, maar monotone celpopulatie die microfollikels vormen.
40X

Afbeelding 34
Folliculair neoplasma, schildklier FNA, celblok.
De folliculaire cellen hebben ronde kernen met anisonucleose en enigszins grove chromatineaggregaten.
100X
Afbeelding 34
Folliculair neoplasma, schildklier FNA, celblok.
De folliculaire cellen hebben ronde kernen met anisonucleose en enigszins grove chromatineaggregaten.
100X

Afbeelding 35
Folliculair neoplasma, schildklier FNA, ThinPrep®.
Hier is een andere patiënt met uniforme microfollikels.
20X
Afbeelding 35
Folliculair neoplasma, schildklier FNA, ThinPrep®.
Hier is een andere patiënt met uniforme microfollikels.
20X

Afbeelding 36
Folliculair neoplasma, schildklier FNA, ThinPrep®.
Met sterkere vergroting kunt u ronde kernen met enigszins grof chromatine zien.
60X
Afbeelding 36
Folliculair neoplasma, schildklier FNA, ThinPrep®.
Met sterkere vergroting kunt u ronde kernen met enigszins grof chromatine zien.
60X

Afbeelding 37
Folliculair neoplasma, schildklier FNA, celblok.
Een microbiopsiefragment van dezelfde patiënt als in afbeelding 35-36 toont een monotoon microfolliculair groeipatroon. Er is geen hemosiderine of cystische degeneratie zichtbaar.
10X
Afbeelding 37
Folliculair neoplasma, schildklier FNA, celblok.
Een microbiopsiefragment van dezelfde patiënt als in afbeelding 35-36 toont een monotoon microfolliculair groeipatroon. Er is geen hemosiderine of cystische degeneratie zichtbaar.
10X

Afbeelding 38
Folliculair neoplasma, schildklier FNA, celblok.
Let op de robuuste cilindervormige cellen die monotone microfollikels vormen. Er is geen colloïde aanwezig.
40X
Afbeelding 38
Folliculair neoplasma, schildklier FNA, celblok.
Let op de robuuste cilindervormige cellen die monotone microfollikels vormen. Er is geen colloïde aanwezig.
40X

Afbeelding 39
Folliculair neoplasma, schildklier FNA, celblok.
Bij een sterkere vergroting kunnen ronde, regelmatige kernen met enigszins grove chromatineaggregaten worden waargenomen.
100X
Afbeelding 39
Folliculair neoplasma, schildklier FNA, celblok.
Bij een sterkere vergroting kunnen ronde, regelmatige kernen met enigszins grove chromatineaggregaten worden waargenomen.
100X

Afbeelding 40
Folliculair neoplasma, schildklier FNA, ThinPrep®.
Dit is een andere patiënt dan op het voorgaande plaatje; u ziet een monotone populatie folliculaire cellen met een microfolliculaire ordening en geen hemosiderine.
20X
Afbeelding 40
Folliculair neoplasma, schildklier FNA, ThinPrep®.
Dit is een andere patiënt dan op het voorgaande plaatje; u ziet een monotone populatie folliculaire cellen met een microfolliculaire ordening en geen hemosiderine.
20X

Afbeelding 41
Folliculair neoplasma, schildklier FNA, ThinPrep®.
Kleine, uniforme, dicht opeengepakte colloïd fragmenten zijn opgenomen in de microfolliculaire groepen en de folliculaire cellen hebben van groep tot groep een soortgelijke morfologie.
40X
Afbeelding 41
Folliculair neoplasma, schildklier FNA, ThinPrep®.
Kleine, uniforme, dicht opeengepakte colloïd fragmenten zijn opgenomen in de microfolliculaire groepen en de folliculaire cellen hebben van groep tot groep een soortgelijke morfologie.
40X

Afbeelding 42
Folliculair neoplasma, schildklier FNA, ThinPrep®.
De kernen van deze folliculaire cellen vertonen geen kenmerken van papillair schildkliercarcinoom. De kernen zijn rond en het chromatine is georganiseerd in frequente niet-lineaire aggregaten.
100X
Afbeelding 42
Folliculair neoplasma, schildklier FNA, ThinPrep®.
De kernen van deze folliculaire cellen vertonen geen kenmerken van papillair schildkliercarcinoom. De kernen zijn rond en het chromatine is georganiseerd in frequente niet-lineaire aggregaten.
100X

Afbeelding 43
Folliculair neoplasma, schildklier FNA, celblok.
Deze afbeelding van de patiënt in afbeelding 40-42 toont een monotone populatie met een microfolliculair groeipatroon zonder hemosiderine of cystische veranderingen.
10X
Afbeelding 43
Folliculair neoplasma, schildklier FNA, celblok.
Deze afbeelding van de patiënt in afbeelding 40-42 toont een monotone populatie met een microfolliculair groeipatroon zonder hemosiderine of cystische veranderingen.
10X

Afbeelding 44
Folliculair neoplasma, schildklier FNA, celblok.
De kernen zijn rond en uniform met grof chromatine. Een omineus kenmerk is de solide rug-tegen-rug organisatie van de folliculaire cellen zonder tussenliggend basaalmembraan.
100X
Afbeelding 44
Folliculair neoplasma, schildklier FNA, celblok.
De kernen zijn rond en uniform met grof chromatine. Een omineus kenmerk is de solide rug-tegen-rug organisatie van de folliculaire cellen zonder tussenliggend basaalmembraan.
100X

Afbeelding 45
Folliculair neoplasma, schildklier FNA, celblok.
Onze niet-gepubliceerde observaties suggereren dat het rug-tegen-rug groeipatroon, dat doet denken aan een cribriform ductaal carcinoom in situ, duidt op het insulaire type van een slecht gedifferentieerd schildkliercarcinoom. De resectie van dit specimen toonde inderdaad een insulair carcinoom met wijdverspreide angio-invasie.
40X
Afbeelding 45
Folliculair neoplasma, schildklier FNA, celblok.
Onze niet-gepubliceerde observaties suggereren dat het rug-tegen-rug groeipatroon, dat doet denken aan een cribriform ductaal carcinoom in situ, duidt op het insulaire type van een slecht gedifferentieerd schildkliercarcinoom. De resectie van dit specimen toonde inderdaad een insulair carcinoom met wijdverspreide angio-invasie.
40X

Afbeelding 46
Folliculair neoplasma, schildklier FNA, celblok.
Linksboven kleurt een losgekomen cluster kleine bloedvaten positief voor CD34. Let op de afwezigheid van kleuring in de rug-tegen-rug groep folliculaire cellen (pijl). De grootschalige rug-tegen-rug groei zonder tussenliggend basaalmembraan/capillair netwerk is in feite het diagnostische insulaire patroon dat door chirurgische pathologen wordt herkend.
10X
Afbeelding 46
Folliculair neoplasma, schildklier FNA, celblok.
Linksboven kleurt een losgekomen cluster kleine bloedvaten positief voor CD34. Let op de afwezigheid van kleuring in de rug-tegen-rug groep folliculaire cellen (pijl). De grootschalige rug-tegen-rug groei zonder tussenliggend basaalmembraan/capillair netwerk is in feite het diagnostische insulaire patroon dat door chirurgische pathologen wordt herkend.
10X

Afbeelding 47
Folliculair neoplasma, schildklier FNA, ThinPrep®.
Er is een solide uitziend groeipatroon aanwezig zonder colloïde.
60X
Afbeelding 47
Folliculair neoplasma, schildklier FNA, ThinPrep®.
Er is een solide uitziend groeipatroon aanwezig zonder colloïde.
60X

Afbeelding 48
Folliculair neoplasma, schildklier FNA, ThinPrep®.
Een ander soortgelijk ‘klonaal uitziende’ cluster, met soortgelijke nucleaire en cytoplasmische kenmerken is aanwezig.
60X
Afbeelding 48
Folliculair neoplasma, schildklier FNA, ThinPrep®.
Een ander soortgelijk ‘klonaal uitziende’ cluster, met soortgelijke nucleaire en cytoplasmische kenmerken is aanwezig.
60X

Afbeelding 49
Folliculair neoplasma, schildklier FNA, celblok.
Deze afbeelding van de patiënt in afbeelding 47-48 toont een relatief cohesieve, uniforme, klonaal uitziende populatie met microfolliculaire architectuur, die consistent is met een neoplasma.
10X
Afbeelding 49
Folliculair neoplasma, schildklier FNA, celblok.
Deze afbeelding van de patiënt in afbeelding 47-48 toont een relatief cohesieve, uniforme, klonaal uitziende populatie met microfolliculaire architectuur, die consistent is met een neoplasma.
10X

Afbeelding 50
Folliculair neoplasma, schildklier FNA, celblok.
De kernen vertonen focaal lege plekken in het chromatine (pijl). Dit proces is duidelijk neoplastisch, maar kan het ook een folliculair variant zijn van een papillair schildkliercarcinoom?
40X
Afbeelding 50
Folliculair neoplasma, schildklier FNA, celblok.
De kernen vertonen focaal lege plekken in het chromatine (pijl). Dit proces is duidelijk neoplastisch, maar kan het ook een folliculair variant zijn van een papillair schildkliercarcinoom?
40X

Afbeelding 51
Folliculair neoplasma, schildklier FNA, celblok.
Hoewel de meeste kernen rond zijn en enkele grove chromatine-aggregaten vertonen, zijn er een paar dunne nucleaire groeven aanwezig en sommige kernen bevatten fijn chromatine (open pijl).
100X
Afbeelding 51
Folliculair neoplasma, schildklier FNA, celblok.
Hoewel de meeste kernen rond zijn en enkele grove chromatine-aggregaten vertonen, zijn er een paar dunne nucleaire groeven aanwezig en sommige kernen bevatten fijn chromatine (open pijl).
100X

Afbeelding 52
Folliculair neoplasma, schildklier FNA, celblok.
Immunokleuring voor cytokeratine 19 is negatief. Hoewel er geen definitieve markers zijn voor papillair schildkliercarcinoom. helpt de afwezigheid van cytokeratine 19 enigszins bij de uitsluiting van papillair schildkliercarcinoom. Reactieve veranderingen die kunnen lijken op papillair schildkliercarcinoom zijn vaak positief voor cytokeratine 19; positieve kleuring moet dus voorzichtig worden geïnterpreteerd.
20X
Afbeelding 52
Folliculair neoplasma, schildklier FNA, celblok.
Immunokleuring voor cytokeratine 19 is negatief. Hoewel er geen definitieve markers zijn voor papillair schildkliercarcinoom. helpt de afwezigheid van cytokeratine 19 enigszins bij de uitsluiting van papillair schildkliercarcinoom. Reactieve veranderingen die kunnen lijken op papillair schildkliercarcinoom zijn vaak positief voor cytokeratine 19; positieve kleuring moet dus voorzichtig worden geïnterpreteerd.
20X

Afbeelding 53
Folliculair neoplasma, schildklier FNA, celblok.
Een positieve thyroglobulinekleuring kan helpen om medullaire schildkliercarcinoom uit te sluiten in een patiënt die geen duidelijk colloïde heeft.
20X
Afbeelding 53
Folliculair neoplasma, schildklier FNA, celblok.
Een positieve thyroglobulinekleuring kan helpen om medullaire schildkliercarcinoom uit te sluiten in een patiënt die geen duidelijk colloïde heeft.
20X

Afbeelding 54
Vermoeden van folliculaire variant van papillair schildkliercarcinoom, schildklier FNA, ThinPrep®.
Meerdere kleine dichte colloïdefragmenten zijn zichtbaar; dit is consistent met een microfolliculaire architectuur. Aan de randen van het fragment, vertonen kernen open chromatine en enige onregelmatigheid in de vorm (pijl).
100X
Afbeelding 54
Vermoeden van folliculaire variant van papillair schildkliercarcinoom, schildklier FNA, ThinPrep®.
Meerdere kleine dichte colloïdefragmenten zijn zichtbaar; dit is consistent met een microfolliculaire architectuur. Aan de randen van het fragment, vertonen kernen open chromatine en enige onregelmatigheid in de vorm (pijl).
100X

Afbeelding 55
Vermoeden van folliculaire variant van papillair schildkliercarcinoom, schildklier FNA, ThinPrep®.
Vergeleken met de folliculaire neoplasmen in de voorgaande afbeeldingen, is het chromatine minder grof in deze microfolliculaire groep, en er is sprake van lichte anisonucleose.
100X
Afbeelding 55
Vermoeden van folliculaire variant van papillair schildkliercarcinoom, schildklier FNA, ThinPrep®.
Vergeleken met de folliculaire neoplasmen in de voorgaande afbeeldingen, is het chromatine minder grof in deze microfolliculaire groep, en er is sprake van lichte anisonucleose.
100X

Afbeelding 56
Vermoeden van folliculaire variant van papillair schildkliercarcinoom, schildklier FNA, ThinPrep®.
De nucleaire envelop is uitgesproken onregelmatig (pijl).
100X
Afbeelding 56
Vermoeden van folliculaire variant van papillair schildkliercarcinoom, schildklier FNA, ThinPrep®.
De nucleaire envelop is uitgesproken onregelmatig (pijl).
100X

Afbeelding 57
Vermoeden van folliculaire variant van papillair schildkliercarcinoom, schildklier FNA, celblok.
Kleine vergroting van de patiënt in afbeelding 54-56 vertoont verschillende klonaal uitziende fragmenten met een hoofdzakelijk microfolliculaire architectuur.
40X
Afbeelding 57
Vermoeden van folliculaire variant van papillair schildkliercarcinoom, schildklier FNA, celblok.
Kleine vergroting van de patiënt in afbeelding 54-56 vertoont verschillende klonaal uitziende fragmenten met een hoofdzakelijk microfolliculaire architectuur.
40X

Afbeelding 58
Vermoeden van folliculaire variant van papillair schildkliercarcinoom, schildklier FNA, celblok.
Twee van de follikels lijken bij deze vergroting macrofolliculair (ten minste 10 folliculaire celdiameters). Er zijn geen duidelijke papillaire structuren. Papillaire schildkliercarcinomen hoeven geen papillaire architectuur te vertonen; ze kunnen macrofolliculair zijn. Het bepalende kenmerk van papillair schildkliercarcinoom is gelegen in de celmorfologie, waarvoor een sterkere vergroting nodig is.
10X
Afbeelding 58
Vermoeden van folliculaire variant van papillair schildkliercarcinoom, schildklier FNA, celblok.
Twee van de follikels lijken bij deze vergroting macrofolliculair (ten minste 10 folliculaire celdiameters). Er zijn geen duidelijke papillaire structuren. Papillaire schildkliercarcinomen hoeven geen papillaire architectuur te vertonen; ze kunnen macrofolliculair zijn. Het bepalende kenmerk van papillair schildkliercarcinoom is gelegen in de celmorfologie, waarvoor een sterkere vergroting nodig is.
10X

Afbeelding 59
Vermoeden van folliculaire variant van papillair schildkliercarcinoom, schildklier FNA, celblok.
Erg fijn chromatine en lichte onregelmatigheid van de nucleaire envelop zijn aanwezig, vermoeden van folliculaire variant van papillair schildkliercarcinoom. Let op hoe fijne lineaire rijen chromatine (kernen gemarkeerd met pijlen) gemakkelijker waargenomen kunnen worden dan ronde aggregaten van chromatine. De lineaire rijen vertegenwoordigen erg oppervlakkige vouwen in de nucleaire envelop.
100X
Afbeelding 59
Vermoeden van folliculaire variant van papillair schildkliercarcinoom, schildklier FNA, celblok.
Erg fijn chromatine en lichte onregelmatigheid van de nucleaire envelop zijn aanwezig, vermoeden van folliculaire variant van papillair schildkliercarcinoom. Let op hoe fijne lineaire rijen chromatine (kernen gemarkeerd met pijlen) gemakkelijker waargenomen kunnen worden dan ronde aggregaten van chromatine. De lineaire rijen vertegenwoordigen erg oppervlakkige vouwen in de nucleaire envelop.
100X

Afbeelding 60
Vermoeden van folliculaire variant van papillair schildkliercarcinoom, schildklier FNA, celblok.
De scheidingslijn tussen folliculair type en papillair type epitheel is nog niet goed gedefinieerd. Histologische coupes van schildklier FNA verschaffen een gemeenschappelijk platform voor chirurgische pathologen en cythopathologen om de criteria te definiëren. De resectie van deze patiënt was gediagnosticeerd als de folliculaire variant van papillair schildkliercarcinoom.
100X
Afbeelding 60
Vermoeden van folliculaire variant van papillair schildkliercarcinoom, schildklier FNA, celblok.
De scheidingslijn tussen folliculair type en papillair type epitheel is nog niet goed gedefinieerd. Histologische coupes van schildklier FNA verschaffen een gemeenschappelijk platform voor chirurgische pathologen en cythopathologen om de criteria te definiëren. De resectie van deze patiënt was gediagnosticeerd als de folliculaire variant van papillair schildkliercarcinoom.
100X

Afbeelding 61
Vermoeden van papillair schildkliercarcinoom, schildklier FNA, ThinPrep®.
Een cluster met een microfolliculaire architectuur en dicht opeengepakt colloïde toont kernen met fijn chromatine, ovale vorm en enkele groeven. Er is hemosiderine aanwezig, een bevinding die voor papillair schildkliercarcinoom pleit in plaats van een folliculair type neoplasma.
60X
Afbeelding 61
Vermoeden van papillair schildkliercarcinoom, schildklier FNA, ThinPrep®.
Een cluster met een microfolliculaire architectuur en dicht opeengepakt colloïde toont kernen met fijn chromatine, ovale vorm en enkele groeven. Er is hemosiderine aanwezig, een bevinding die voor papillair schildkliercarcinoom pleit in plaats van een folliculair type neoplasma.
60X

Afbeelding 62
Vermoeden van papillair schildkliercarcinoom, schildklier FNA, celblok.
Dit sterk vergrote plaatje van dezelfde patiënt als afbeelding 61 vertoont soortgelijke kenmerken. Let op het fijne chromatine dat in dunne lijnen georganiseerd is en oppervlakkige vouwen in de nucleaire envelop voorstellen.
100X
Afbeelding 62
Vermoeden van papillair schildkliercarcinoom, schildklier FNA, celblok.
Dit sterk vergrote plaatje van dezelfde patiënt als afbeelding 61 vertoont soortgelijke kenmerken. Let op het fijne chromatine dat in dunne lijnen georganiseerd is en oppervlakkige vouwen in de nucleaire envelop voorstellen.
100X

Afbeelding 63
Vermoeden van papillair schildkliercarcinoom, schildklier FNA, celblok.
Een kleuring met cytokeratine 19 is positief, hetgeen sterk doet vermoeden dat we hier te maken hebben met een papillair schildkliercarcinoom.
20X
Afbeelding 62
Vermoeden van papillair schildkliercarcinoom, schildklier FNA, celblok.
Een kleuring met cytokeratine 19 is positief, hetgeen sterk doet vermoeden dat we hier te maken hebben met een papillair schildkliercarcinoom.
20X

Afbeelding 64
Papillair schildkliercarcinoom, schildklier FNA, ThinPrep®.
Dit wordt gekenmerkt door een scherp gedefinieerde intranucleaire cytoplasmische inclusie (pijl), erg fijne chromatinetextuur, onregelmatige contouren van de kernen en ovale kernen. Let op de brede platte 2-dimensionale laag, die duidt op een macrofolliculaire architectuur, hetgeen gebruikelijk is in papillaire schildkliercarcinomen.
60X
Afbeelding 64
Papillair schildkliercarcinoom, schildklier FNA, ThinPrep®.
Dit wordt gekenmerkt door een scherp gedefinieerde intranucleaire cytoplasmische inclusie (pijl), erg fijne chromatinetextuur, onregelmatige contouren van de kernen en ovale kernen. Let op de brede platte 2-dimensionale laag, die duidt op een macrofolliculaire architectuur, hetgeen gebruikelijk is in papillaire schildkliercarcinomen.
60X

Afbeelding 65
Papillair schildkliercarcinoom, schildklier FNA, celblok.
De aanwezigheid van overvloedig colloïde sluit een papillair schildkliercarcinoom niet uit.
10X
Afbeelding 65
Papillair schildkliercarcinoom, schildklier FNA, celblok.
De aanwezigheid van overvloedig colloïde sluit een papillair schildkliercarcinoom niet uit.
10X

Afbeelding 66
Papillair schildkliercarcinoom, schildklier FNA, celblok.
De lange strook aan de rechterkant is een macromoleculaire groep die lijkt op die in afbeelding 64. Let op het fijne chromatine en de onregelmatige nucleaire envelop.
60X
Afbeelding 66
Papillair schildkliercarcinoom, schildklier FNA, celblok.
De lange strook aan de rechterkant is een macromoleculaire groep die lijkt op die in afbeelding 64. Let op het fijne chromatine en de onregelmatige nucleaire envelop.
60X

Afbeelding 67
Papillair schildkliercarcinoom, schildklier FNA, celblok.
Een scherp gedemarqueerde intranucleaire cytoplasmische inclusie (pijl), fijne chromatinetextuur en een onregelmatige nucleaire envelop zijn de belangrijkste kenmerken voor het diagnosticeren van een papillair schildkliercarcinoom.
100X
Afbeelding 67
Papillair schildkliercarcinoom, schildklier FNA, celblok.
Een scherp gedemarqueerde intranucleaire cytoplasmische inclusie (pijl), fijne chromatinetextuur en een onregelmatige nucleaire envelop zijn de belangrijkste kenmerken voor het diagnosticeren van een papillair schildkliercarcinoom.
100X

Afbeelding 68
Papillair schildkliercarcinoom, schildklier FNA, celblok.
Zowel papillaire schildkliercarcinomen en benigne hyperplastische nodulen kunnen papillaire structuren bevatten. De opeenstapeling van de kernen doet een papillair schildkliercarcinoom vermoeden.
20X
Afbeelding 68
Papillair schildkliercarcinoom, schildklier FNA, celblok.
Zowel papillaire schildkliercarcinomen en benigne hyperplastische nodulen kunnen papillaire structuren bevatten. De opeenstapeling van de kernen doet een papillair schildkliercarcinoom vermoeden.
20X

Afbeelding 69
Papillair schildkliercarcinoom, schildklier FNA, celblok.
Een sterkere vergroting van afbeelding 68 toont diagnostische kenmerken van opeengestapelde kernen met nucleaire groeven, erg fijne chromatine, een zeldzame intranucleaire cytoplasmische inclusie (open pijl) en hier en daar een nauwelijks merkbaar verlies aan polariteit.
60X
Afbeelding 69
Papillair schildkliercarcinoom, schildklier FNA, celblok.
Een sterkere vergroting van afbeelding 68 toont diagnostische kenmerken van opeengestapelde kernen met nucleaire groeven, erg fijne chromatine, een zeldzame intranucleaire cytoplasmische inclusie (open pijl) en hier en daar een nauwelijks merkbaar verlies aan polariteit.
60X

Afbeelding 70
Benigne, hyperplastisch/adenomatoïde nodule, schildklier FNA, celblok.
Papillaire structuren zonder de nucleaire kenmerken van papillair schildkliercarcinoom pleiten sterk voor een benigne nodule. Vergeleken met een papillair schildkliercarcinoom zijn de kernen rond en gelijkmatig verspreid en hebben een uniforme hoeveelheid apicaal cytoplasma. [6]
40X
Afbeelding 70
Benigne, hyperplastisch/adenomatoïde nodule, schildklier FNA, celblok.
Papillaire structuren zonder de nucleaire kenmerken van papillair schildkliercarcinoom pleiten sterk voor een benigne nodule. Vergeleken met een papillair schildkliercarcinoom zijn de kernen rond en gelijkmatig verspreid en hebben een uniforme hoeveelheid apicaal cytoplasma. [6]
40X

Afbeelding 71
Papillair schildkliercarcinoom, schildklier FNA, ThinPrep®.
Let op de abnormale polariteit van de kernen (pijl) die ook nucleaire groeven en fijn chromatine vertonen.
100X
Afbeelding 71
Papillair schildkliercarcinoom, schildklier FNA, ThinPrep®.
Let op de abnormale polariteit van de kernen (pijl) die ook nucleaire groeven en fijn chromatine vertonen.
100X

Afbeelding 72
Papillair schildkliercarcinoom, schildklier FNA, celblok.
Abnormale nucleaire polariteit in twee aangrenzende cellen (pijlen) kan worden waargenomen in een papillair fragment, lijkend op dat in afbeelding 71.
60X
Afbeelding 72
Papillair schildkliercarcinoom, schildklier FNA, celblok.
Abnormale nucleaire polariteit in twee aangrenzende cellen (pijlen) kan worden waargenomen in een papillair fragment, lijkend op dat in afbeelding 71.
60X

Afbeelding 73
Papillair schildkliercarcinoom, schildklier FNA, celblok.
Blauwachtige gecalcificeerde psammoma lichaampjes leiden tot een sterk vermoeden van papillair schildkliercarcinoom, maar zijn niet voldoende voor een diagnose.
60X
Afbeelding 73
Papillair schildkliercarcinoom, schildklier FNA, celblok.
Blauwachtige gecalcificeerde psammoma lichaampjes leiden tot een sterk vermoeden van papillair schildkliercarcinoom, maar zijn niet voldoende voor een diagnose.
60X

Afbeelding 74
Papillair schildkliercarcinoom, schildklier FNA, celblok.
Open chromatine, zeldzame nucleaire groeven en nauwelijks waarneembare abnormale nucleaire polariteit zijn aanwezig. Let op de cystische achtergrond – een vaak voorkomend kenmerk bij papillair schildkliercarcinoom.
60X
Afbeelding 74
Papillair schildkliercarcinoom, schildklier FNA, celblok.
Open chromatine, zeldzame nucleaire groeven en nauwelijks waarneembare abnormale nucleaire polariteit zijn aanwezig. Let op de cystische achtergrond – een vaak voorkomend kenmerk bij papillair schildkliercarcinoom.
60X

Afbeelding 75
Papillair schildkliercarcinoom, schildklier FNA, ThinPrep®.
Uniforme leeg uitziende cytoplasmische vacuolen kunnen soms worden waargenomen bij papillaire schildkliercarcinomen. Typerende nucleaire kenmerken van een papillair schildkliercarcinoom zijn aanwezig met een prominente intranucleaire inclusie (pijl).
60X
Afbeelding 75
Papillair schildkliercarcinoom, schildklier FNA, ThinPrep®.
Uniforme leeg uitziende cytoplasmische vacuolen kunnen soms worden waargenomen bij papillaire schildkliercarcinomen. Typerende nucleaire kenmerken van een papillair schildkliercarcinoom zijn aanwezig met een prominente intranucleaire inclusie (pijl).
60X

Afbeelding 76
Papillair schildkliercarcinoom, schildklier FNA, ThinPrep®.
Het gevacuoliseerde cytoplasma kan er soms toe leiden dat de cellen van het papillaire schildkliercarcinoom er histiocytair uitzien.
60X
Afbeelding 76
Papillair schildkliercarcinoom, schildklier FNA, ThinPrep®.
Het gevacuoliseerde cytoplasma kan er soms toe leiden dat de cellen van het papillaire schildkliercarcinoom er histiocytair uitzien.
60X

Afbeelding 77
Papillair schildkliercarcinoom, schildklier FNA, celblok.
Histiocytaire carcinoomcellen met uniforme lege cytoplasmische vacuolen die lijken op de cellen in afbeelding 76 worden weergegeven.
60X
Afbeelding 77
Papillair schildkliercarcinoom, schildklier FNA, celblok.
Histiocytaire carcinoomcellen met uniforme lege cytoplasmische vacuolen die lijken op de cellen in afbeelding 76 worden weergegeven.
60X

Afbeelding 78
Papillair schildkliercarcinoom, schildklier FNA, ThinPrep®.
Squameuze metaplasie is een andere veel voorkomende cytoplasmische verandering in papillair schildkliercarcinoom.
60X
Afbeelding 78
Papillair schildkliercarcinoom, schildklier FNA, ThinPrep®.
Squameuze metaplasie is een andere veel voorkomende cytoplasmische verandering in papillair schildkliercarcinoom.
60X

Afbeelding 79
Papillair schildkliercarcinoom, schildklier FNA, celblok.
Deze groep van dezelfde patiënt als in afbeelding 78 vertoont een soortgelijke, prominente squameuze metaplasie.
40X
Afbeelding 79
Papillair schildkliercarcinoom, schildklier FNA, celblok.
Deze groep van dezelfde patiënt als in afbeelding 78 vertoont een soortgelijke, prominente squameuze metaplasie.
40X

Afbeelding 80
Medullair schildkliercarcinoom, schildklier FNA, ThinPrep®.
Mild pleomorfe cellen met excentrische kernen zijn aanwezig met doorzichtige, dichtopeengepakte fragmenten amyloïde.
60X
Afbeelding 80
Medullair schildkliercarcinoom, schildklier FNA, ThinPrep®.
Mild pleomorfe cellen met excentrische kernen zijn aanwezig met doorzichtige, dichtopeengepakte fragmenten amyloïde.
60X

Afbeelding 81
Medullair schildkliercarcinoom, schildklier FNA, ThinPrep®.
Er is sprake van enigszins grof chromatine, excentrische kernen en lichte variatie in de celmorfologie van cel tot cel.
60X
Afbeelding 81
Medullair schildkliercarcinoom, schildklier FNA, ThinPrep®.
Er is sprake van enigszins grof chromatine, excentrische kernen en lichte variatie in de celmorfologie van cel tot cel.
60X

Afbeelding 82
Medullair schildkliercarcinoom, schildklier FNA, ThinPrep®.
Typerend grof ‘peper en zout’ chromatine is aanwezig.
60X
Afbeelding 82
Medullair schildkliercarcinoom, schildklier FNA, ThinPrep®.
Typerend grof ‘peper en zout’ chromatine is aanwezig.
60X

Afbeelding 83
Medullair schildkliercarcinoom, schildklier FNA, celblok.
Een solide groeipatroon is aanwezig met een fragment amyloïde. Let op de excentrische kernen met een plasmacytoïde uiterlijk en lichte nucleaire variabiliteit.
40X
Afbeelding 83
Medullair schildkliercarcinoom, schildklier FNA, celblok.
Een solide groeipatroon is aanwezig met een fragment amyloïde. Let op de excentrische kernen met een plasmacytoïde uiterlijk en lichte nucleaire variabiliteit.
40X

Afbeelding 84
Medullair schildkliercarcinoom, schildklier FNA, celblok.
Kleine aggregaten amyloïd zijn aanwezig in een licht pleomorfe populatie.
40X
Afbeelding 84
Medullair schildkliercarcinoom, schildklier FNA, celblok.
Kleine aggregaten amyloïd zijn aanwezig in een licht pleomorfe populatie.
40X

Afbeelding 85
Medullair schildkliercarcinoom, schildklier FNA, celblok.
‘Peper en zout’ chromatine zoals in afbeelding 82 wordt afgebeeld.
60X
Afbeelding 85
Medullair schildkliercarcinoom, schildklier FNA, celblok.
‘Peper en zout’ chromatine zoals in afbeelding 82 wordt afgebeeld.
60X

Afbeelding 86
Medullair schildkliercarcinoom, schildklier FNA, celblok.
Deze kleuring van het weefsel in afbeelding 80-85 met Congo-rood markeert een fragment amyloïde.
60X
Afbeelding 86
Medullair schildkliercarcinoom, schildklier FNA, celblok.
Deze kleuring van het weefsel in afbeelding 80-85 met Congo-rood markeert een fragment amyloïde.
60X

Afbeelding 87
Medullair schildkliercarcinoom, schildklier FNA, celblok.
Onder gepolariseerd licht vertoont het Congo-rood gekleurde amyloïde de kenmerkende groenachtige dubbele breking.
40X
Afbeelding 87
Medullair schildkliercarcinoom, schildklier FNA, celblok.
Onder gepolariseerd licht vertoont het Congo-rood gekleurde amyloïde de kenmerkende groenachtige dubbele breking.
40X

Afbeelding 88
Medullair schildkliercarcinoom, schildklier FNA, celblok.
Deze groepen van de patiënt in afbeelding 80-86 kleuren positief voor calcitonine.
20X
Afbeelding 88
Medullair schildkliercarcinoom, schildklier FNA, celblok.
Deze groepen van de patiënt in afbeelding 80-86 kleuren positief voor calcitonine.
20X

Afbeelding 89
Medullair schildkliercarcinoom, schildklier FNA, celblok.
Immunoreactiviteit voor synaptophysine is ook aanwezig in medullaire schildkliercarcinomen.
20X
Afbeelding 89
Medullair schildkliercarcinoom, schildklier FNA, celblok.
Immunoreactiviteit voor synaptophysine is ook aanwezig in medullaire schildkliercarcinomen.
20X

Afbeelding 90
Medullair schildkliercarcinoom, schildklier FNA, ThinPrep®.
Een andere patiënt dan de vorige vertoont een enigszins pleomorfere populatie die varieert van plasmacytoïde tot focaal spoelvormig.
60X
Afbeelding 90
Medullair schildkliercarcinoom, schildklier FNA, ThinPrep®.
Een andere patiënt dan de vorige vertoont een enigszins pleomorfere populatie die varieert van plasmacytoïde tot focaal spoelvormig.
60X

Afbeelding 91
Medullair schildkliercarcinoom, schildklier FNA, ThinPrep®.
Een intranucleaire cytoplasmische inclusie is aanwezig in een van de cellen van deze mild pleomorfe populatie.
60X
Afbeelding 91
Medullair schildkliercarcinoom, schildklier FNA, ThinPrep®.
Een intranucleaire cytoplasmische inclusie is aanwezig in een van de cellen van deze mild pleomorfe populatie.
60X

Afbeelding 92
Medullair schildkliercarcinoom, schildklier FNA, ThinPrep®.
Spoelvormige tumorcellen kunnen ook worden waargenomen.
40X
Afbeelding 92
Medullair schildkliercarcinoom, schildklier FNA, ThinPrep®.
Spoelvormige tumorcellen kunnen ook worden waargenomen.
40X

Afbeelding 93
Medullair schildkliercarcinoom, schildklier FNA, celblok.
Dezelfde patiënt als in afbeelding 90-92 toont een sterk positieve immunokleuring voor calcitonine.
40X
Afbeelding 93
Medullair schildkliercarcinoom, schildklier FNA, celblok.
Dezelfde patiënt als in afbeelding 90-92 toont een sterk positieve immunokleuring voor calcitonine.
40X